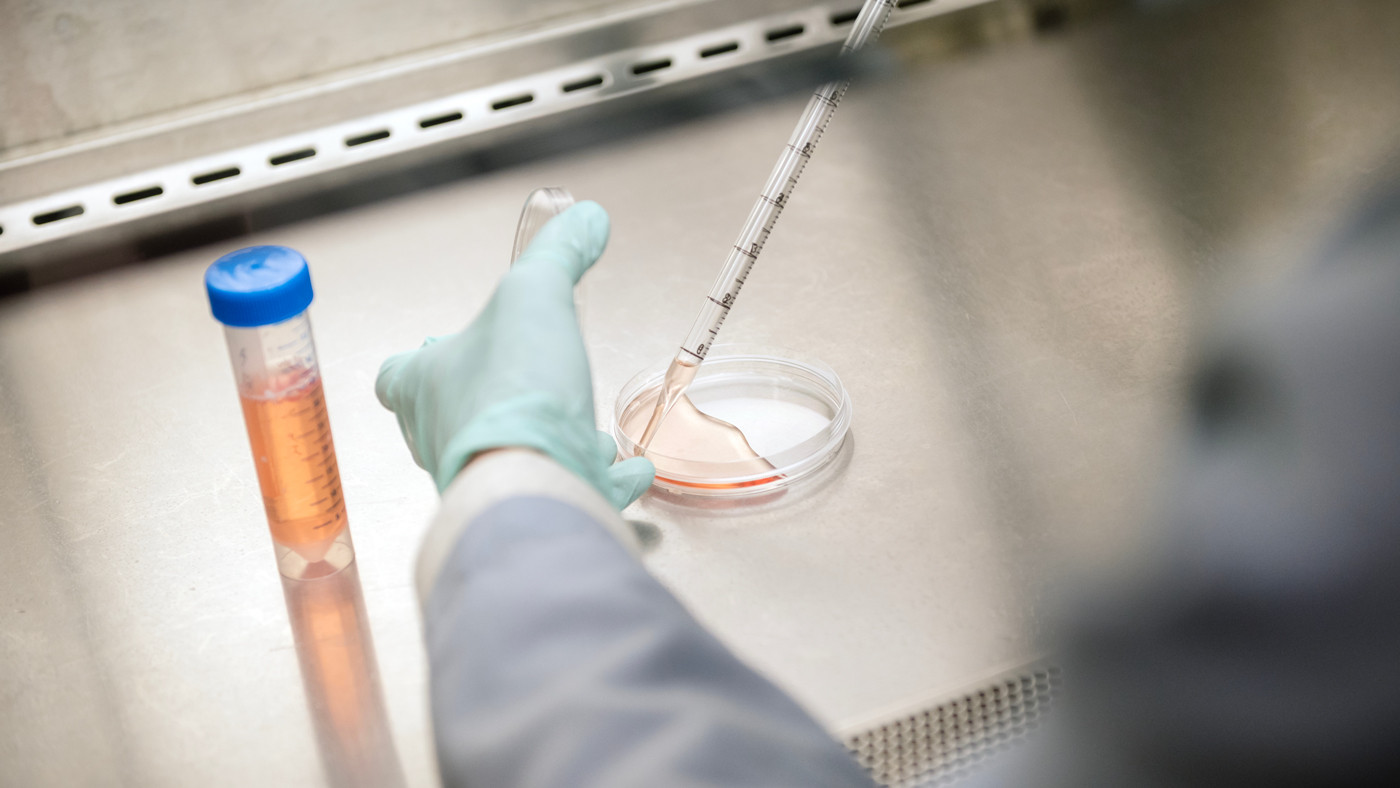
Scientist working in the Conklin Lab at Gladstone Institutes

Gladstone NOW: The Campaign Join Us on the Journey✕
A team of scientists at Gladstone developed a new gene editing method and showed that only a few variations of the therapy could treat the majority of patients with Charcot-Marie-Tooth disease.
Gene editing technologies developed in recent years offer the promise of repairing genetic mutations that cause disease. But putting these therapies to use typically requires creating a separate treatment tailored to each disease-causing mutation—an approach that becomes impractical given that a single gene can harbor dozens or even hundreds of different mutations.
Now, scientists at Gladstone Institutes and UC San Francisco (UCSF) have developed a new strategy that removes the mutated copy of a gene—or critical portions of it—from cells while leaving the healthy copy intact. The approach could be 20 to 40 times more efficient than personalizing individual therapies for each mutation, with just a few variations of the therapy treating nearly all patients with an inherited disorder.
In a new study published in Molecular Therapy, the researchers used their approach, called “haplotype editing,” to restore function to human nerve cells from patients with Charcot-Marie-Tooth (CMT) disease, a progressive neurological disorder that affects over 3 million people.
“With this approach, we don’t have to create an entirely new, customized gene editing therapy for every patient,” says Gladstone Senior Investigator Bruce Conklin, MD, co-senior author of the new study. “We’ve not only shown how effective it is for Charcot-Marie-Tooth disease, but also how it can be leveraged to treat hundreds or thousands of other genetic conditions.”
As a way to treat disease-causing mutations, Conklin (in the foreground, with Gokul Ramadoss in the background) and his colleagues developed a new method that removes the mutated copy of a gene from cells while leaving the healthy copy intact.
From One Mutation to Many
People have two copies of most genes—one inherited from their mother, the other from their father. Many genetic diseases happen when someone inherits one defective copy of a gene. Even if the other copy is healthy, the mutated version can disrupt the normal gene’s ability to do its job, like one bad ingredient spoiling an entire recipe.
The advent of gene editing technologies like CRISPR, which can make precise cuts and changes to DNA, has led many researchers to try developing therapies that fix this kind of disease-causing mutation. But for many diseases—including CMT—scaling this up to patients has been a colossal task.
That’s because CMT includes approximately 160 subtypes caused by mutations in more than 130 genes. One form of the disease studied by Gladstone scientists, called CMT2E, is caused by over 50 different mutations in a single gene. So, helping patients would involve developing and testing dozens of therapies to fix each of the different mutations that can cause the disease.
“If we had to create a separate gene editing therapy for every single mutation, we’d need 26 different treatments just to help half of Charcot-Marie-Tooth 2E patients,” says Luke Judge, MD, PhD, professor of pediatrics at UCSF Benioff Children’s Hospital and co-senior author of the study. “We realized we needed a different approach.”

The approach developed by Judge and his team could be 20 to 40 times more efficient for treating inherited disorders than personalizing individual therapies for each mutation.
Conklin and Judge wanted to take advantage of the fact that people can survive with only one copy of many genes, much like you can get by with one kidney. But to remove the mutated copy of a gene and leave behind the healthy one, the researchers had to find a way to differentiate the two. They homed in on common genetic variants called single nucleotide polymorphisms (SNPs) that are scattered throughout the human genome.
Like genetic “zip codes,” these variants are inherited in blocks of DNA called haplotypes. Because people typically inherit different haplotypes from each parent, these SNPs can serve as unique markers that distinguish the mutated chromosome from the healthy one.
The scientists used CRISPR to design pairs of molecular scissors that cut at these SNPs on either side of the mutated gene causing CMT2E, deleting the DNA between them—including the entire gene or critical portions of it. Because each pair of scissors targets specific SNP sequences, the approach selectively removes only the chromosome copy carrying the disease mutation, leaving the healthy copy intact.
Treating Charcot-Marie-Tooth and Beyond
The team tested their approach in stem cells from patients with two different CMT2E-causing mutations. By removing the DNA between sets of common SNPs, the researchers successfully deleted the mutant gene in both patient lines. And when these edited stem cells were matured into motor neurons—the type of brain cell impacted by the disease—the scientists observed dramatic improvements compared to neurons that carry the mutations.
Next, using genetic data from the 1000 Genomes Project, the researchers showed that just four haplotype-targeted therapies could potentially treat most CMT2E patients.
“We’re already applying our approach to other forms of Charcot-Marie-Tooth disease, inherited heart conditions, ALS, and retinal diseases.”
Each therapy targets a different pair of SNPs flanking the gene. Because different people have different SNP patterns, these four therapies together can cover 75 percent of the patient population—with each patient matched to whichever therapy targets SNPs near their mutated gene but not their healthy one.
“This efficiency comes from our shared evolutionary history,” Conklin explains. “Humans are a relatively young species—only about 1.5 million years old—so many SNPs from early human populations remain common today. We’re essentially taking advantage of that gift from human evolution.”
Patients receiving a haplotype editing therapy would need to have their DNA sequenced to determine which set of SNPs are near each of their copies of the mutated gene. But before the therapy can be tested in humans, it needs to be more thoroughly studied in mouse models of CMT2E—work that Conklin and Judge have already begun.
The group is also thinking ahead to how haplotype editing can be used to remove other disease genes that have many mutations, which has so far made them difficult to treat with standard gene editing techniques.
“We expect the conceptual framework we’ve established to be broadly applicable,” says Judge, who is also a visiting scientist at Gladstone. “We’re already applying our approach to other forms of Charcot-Marie-Tooth disease, inherited heart conditions, ALS, and retinal diseases.”
For Media
Julie Langelier
Associate Director, Communications
415.734.5000
Email
About the Study
The paper, “Haplotype editing with CRISPR-Cas9 as a therapeutic approach for dominant-negative missense mutations in NEFL,” was published in the journal Molecular Therapy on November 19, 2025. The authors are Poorvi H. Dua, Bazilco Simon, Chiara Marley, Carissa Feliciano, Hannah Watry, Quinn Cowan, Dylan Steury, Bruce Conklin, and Luke Judge of Gladstone; Abin Abraham of Vanderbilt University; and Erin Gilbertson, Grace Ramey, and John Capra of UC San Francisco.
The work was supported by the Charcot-Marie-Tooth Association, the National Institutes of Health, the American Heart Association, and the California Institute for Regenerative Medicine.
About Gladstone Institutes
Gladstone Institutes is an independent, nonprofit life science research organization that uses visionary science and technology to overcome disease. Established in 1979, it is located in the epicenter of biomedical and technological innovation, in the Mission Bay neighborhood of San Francisco. Gladstone has created a research model that disrupts how science is done, funds big ideas, and attracts the brightest minds.
Featured Experts
Gladstone NOW: The Campaign
Join Us On The Journey
Turning the Tide on Tau: Q&A With Gladstone’s Lennart Mucke
Turning the Tide on Tau: Q&A With Gladstone’s Lennart Mucke
Nearly 20 years after his landmark study uncovered novel roles of tau in Alzheimer’s disease, Gladstone's Lennart Mucke shares his perspective on new clinical data that could transform the future of brain health.
Mucke Lab Alzheimer’s Disease Gladstone Experts Neurological Disease News ReleaseChristina Theodoris Honored in Inaugural Cohort of Young American Scientists
Christina Theodoris Honored in Inaugural Cohort of Young American Scientists
Scientific American recognizes Theodoris for her pioneering work developing artificial intelligence models to find treatments for an array of diseases.
New CRISPR Technique Selectively Shreds Cancer Cells, Including Those of ‘Undruggable’ Cancers
New CRISPR Technique Selectively Shreds Cancer Cells, Including Those of ‘Undruggable’ Cancers
An innovative chromatin-shredding technique shown to destroy cancer cells carrying a prevalent mutation while keeping healthy cells intact.
News Release Research (Publication) Doudna Lab CRISPR/Gene Editing Cancer




